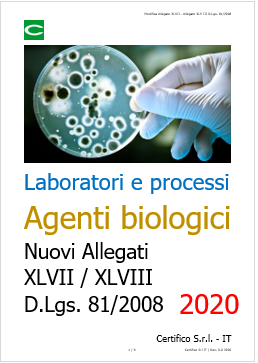
Modifica Allegato XLVII   Allegato XLV III D Lgs  81 2008   2020

Agenti biologici: modifica Allegati XLVII e XLVIII D.Lgs. 81/2008
| ID 12016 | | Visite: 12734 | Documenti Riservati Sicurezza | Permalink: https://www.certifico.com/id/12016 |
Agenti biologici: modifica Allegato XLVII e Allegato XLVIII D.Lgs. 81/2008
ID 12016 - Rev. 1.0 del 11.01.2021 / Documento di lavoro completo allegato
Il Documento allegato, raffronta i nuovi Allegati XLVII e XLVIII del decreto legislativo n. 81 del 9 aprile 2008 inerente nuove misure di contenimento per gli agenti biologici in laboratori e processi modificati dall’Art. 17 del Decreto-Legge 9 novembre 2020 n. 149 rispetto ai sostituiti.
(GU n.319 del 24.12.2020 - SO n. 43).
…
Art. 17. Modifica decreto legislativo n. 81 del 9 aprile 2008
1. Gli allegati XLVII e XLVIII di cui al decreto legislativo 9 aprile 2008, n. 81, sono sostituiti dai seguenti:
ALLEGATO XLVII INDICAZIONI SU MISURE E LIVELLI DI CONTENIMENTO
Le misure previste nel presente allegato devono essere applicate secondo la natura delle attività, la valutazione del rischio per i lavoratori e la natura dell’agente biologico in questione.
Nella tabella, «raccomandato» significa che le misure dovrebbero essere applicate in linea di principio, a meno che i risultati della valutazione del rischio non indichino il contrario.
...
ALLEGATO XLVIII CONTENIMENTO PER PROCESSI INDUSTRIALI
Nella tabella, «raccomandato» significa che le misure dovrebbero essere applicate in linea di principio, a meno che i risultati della valutazione del rischio non indichino il contrario.
Agenti biologici del gruppo 1 Per le attività con agenti biologici del gruppo 1, compresi i vaccini vivi attenuati, devono essere rispettati i principi in materia di sicurezza ed igiene del lavoro.
Agenti biologici dei gruppi 2, 3 e 4 Può essere opportuno selezionare e combinare le prescrizioni di contenimento delle diverse categorie sottoindicate in base ad una valutazione del rischio connesso ad un particolare processo o a una sua parte.
...
Titolo X ESPOSIZIONE AD AGENTI BIOLOGICI
...
Capo II
Obblighi del datore di lavoro
...
Art. 274. Misure specifiche per strutture sanitarie e veterinarie
1. Il datore di lavoro, nelle strutture sanitarie e veterinarie, in sede di valutazione dei rischi, presta particolare attenzione alla possibile presenza di agenti biologici nell'organismo dei pazienti o degli animali e nei relativi campioni e residui e al rischio che tale presenza comporta in relazione al tipo di attivita' svolta.
2. In relazione ai risultati della valutazione, il datore di lavoro definisce e provvede a che siano applicate procedure che consentono di manipolare, decontaminare ed eliminare senza rischi per l'operatore e per la comunita', i materiali ed i rifiuti contaminati.
3. Nelle strutture di isolamento che ospitano pazienti od animali che sono, o potrebbero essere, contaminati da agenti biologici del gruppo 2, 3 o 4, le misure di contenimento da attuare per ridurre al minimo il rischio di infezione sono scelte tra quelle indicate nell' allegato XLVII in funzione delle modalita' di trasmissione dell'agente biologico.
Art. 275. Misure specifiche per i laboratori e gli stabulari
1. Fatto salvo quanto specificatamente previsto all'allegato XLVI, punto 6, nei laboratori comportanti l'uso di agenti biologici dei gruppi 2, 3 o 4 a fini di ricerca, didattici o diagnostici, e nei locali destinati ad animali da laboratorio deliberatamente contaminati con tali agenti, il datore di lavoro adotta idonee misure di contenimento in conformita' all'allegato XLVII.
2. Il datore di lavoro assicura che l'uso di agenti biologici sia eseguito:
a) in aree di lavoro corrispondenti almeno al secondo livello di contenimento, se l'agente appartiene al gruppo 2;
b) in aree di lavoro corrispondenti almeno al terzo livello di contenimento, se l'agente appartiene al gruppo 3;
c) in aree di lavoro corrispondenti almeno al quarto livello di contenimento, se l'agente appartiene al gruppo 4.
3. Nei laboratori comportanti l'uso di materiali con possibile contaminazione da agenti biologici patogeni per l'uomo e nei locali destinati ad animali da esperimento, possibili portatori di tali agenti, il datore di lavoro adotta misure corrispondenti almeno a quelle del secondo livello di contenimento.
4. Nei luoghi di cui ai commi 1 e 3 in cui si fa uso di agenti biologici non ancora classificati, ma il cui uso puo' far sorgere un rischio grave per la salute dei lavoratori, il datore di lavoro adotta misure corrispondenti almeno a quelle del terzo livello di contenimento.
5. Per i luoghi di lavoro di cui ai commi 3 e 4, il Ministero del lavoro, della salute e delle politiche sociali, sentito l'Istituto superiore di sanita', puo' individuare misure di contenimento piu' elevate.
Art. 276. Misure specifiche per i processi industriali
1. Fatto salvo quanto specificatamente previsto all'allegato XLVII, punto 6, nei processi industriali comportanti l'uso di agenti biologici dei gruppi 2, 3 e 4, il datore di lavoro adotta misure opportunamente scelte tra quelle elencate nell'allegato XLVIII, tenendo anche conto dei criteri di cui all'articolo 275.
2. Nel caso di agenti biologici non ancora classificati, il cui uso puo' far sorgere un rischio grave per la salute dei lavoratori, il datore di lavoro adotta misure corrispondenti almeno a quelle del terzo livello di contenimento.
...
...
segue in allegato
Certifico Srl - IT | Rev. 1.0 2020
©Copia autorizzata Abbonati
Matrice Revisioni
| Rev. | Data | Oggetto | Autore |
| 1.0 | 11.01.2021 | Legge 18 dicembre 2020 n. 176 | Certifico Srl |
| 0.0 | 10.11.2020 | --- | Certifico Srl |
| Descrizione | Livello | Dimensione | Downloads | |
|---|---|---|---|---|
| Modifica Allegato XLVII - Allegato XLV III D.Lgs. 81 2008 Rev. 1.0 2020.pdf Certifico Srl - Rev. 1.0 2021 |
222 kB | 77 | ||
| Modifica Allegato XLVII - Allegato XLV III D.Lgs. 81 2008 Rev. 00 2020.pdf Certifico Srl - Rev. 0.0 2020 |
217 kB | 169 |